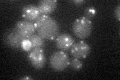
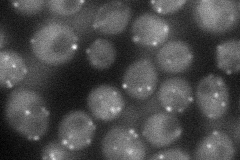
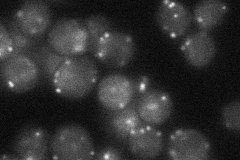
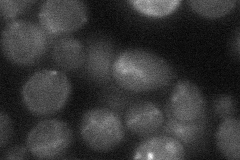
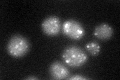

View description
Peroxisomal membrane peroxin and subunit of the docking complex that facilitates the import of peroxisomal matrix proteins; required for peroxisome biogenesis
Localization:
Intensity:
Fold change:
Significance:
-
C’ GFP library in SD
punctate21.35 -
N' NOP1pr-GFP in SD
punctate43.2263 -
N' TEF2pr-mCherry in SD

punctate7.95301 -
N' NATIVEpr-GFP in SD
punctate26.4398 -
N' TEF2pr-VC and Cyto-VN in SD
below threshold23.1217 -
C’ GFP library in SD+DTT
punctate23.471.09No -
C’ GFP library in SD+H2O2

punctate17.240.8Yes -
C’ GFP library in Starvation Media

punctate18.680.87No -
C’ GFP library on the background of Pup2-DaMP

N/A -
C’ GFP library on the background of CCT mutant

N/A0N/AYes
